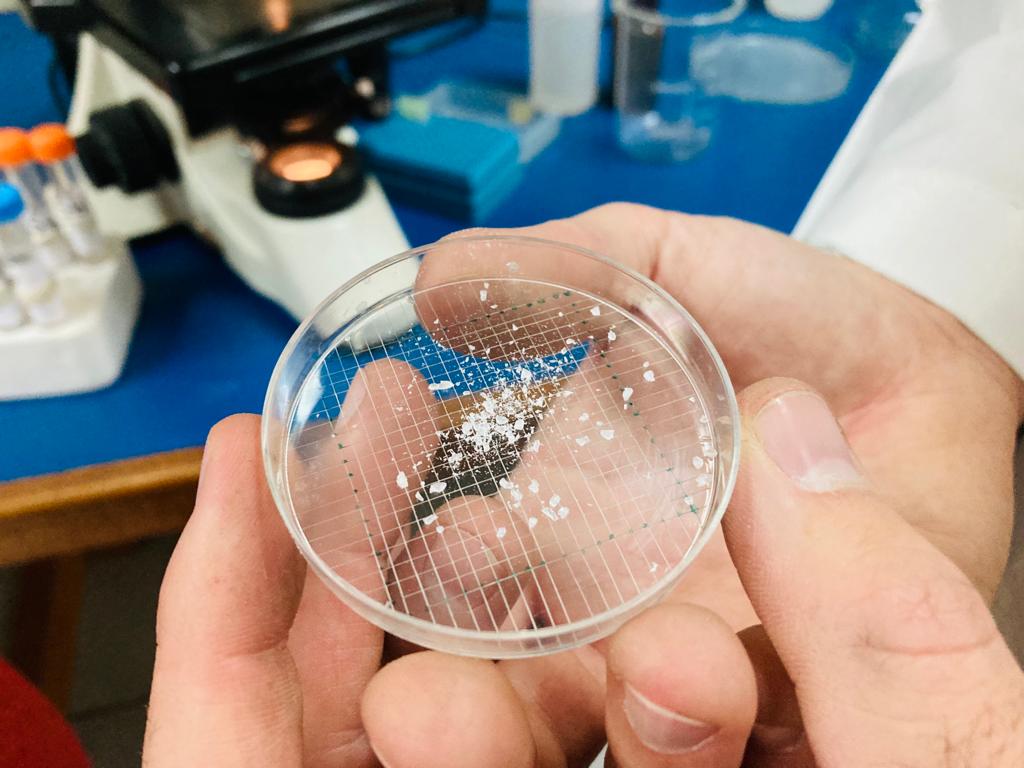

Investigación chilena busca mitigar el efecto de los microplásticos en suelos agrícolas
El Instituto de Investigaciones Agropecuarias (INIA), trabaja en un estudio que permitirá entender los principales movimientos de microplásticos en sistemas agrícolas y evaluar prácticas de manejo que permitan mitigar o disminuir la dispersión de estos contaminantes en el ambiente. Por Equipo Redagrícola Hace ya cinco años, investigadores del Centro Regional de Investigación La Platina del Instituto de Investigaciones Agropecuarias (INIA), apoyados por la Universidad de Wageningen (Países Bajos), realizó los primeros estudios que revelaron el rol que cumplen los lodos provenientes de plantas de tratamiento de aguas servidas como agentes transportadores de microplásticos a sistemas agrícolas. Desde ese entonces, INIA ha liderado investigaciones pioneras a nivel mundial sobre la contaminación de suelos por microplásticos desde que esta problemática capturó la atención de la comunidad científica. Estos primeros estudios se han expandido, publicándose el año pasado un trabajo liderado por el mismo equipo de INIA sobre la presencia y distribución de microplásticos en la Región Metropolitana. Al respecto, el investigador de La Platina, Fabio Corradini, comenta que en este estudio observaron una mayor acumulación de contaminantes en suelos cultivados respecto a cualquier otro uso de suelo. A pesar de la evidencia, los resultados del estudio plantearon nuevas interrogantes. Al respecto, el Dr. Corradini señala que “los estudios que hemos realizado hasta el momento se han enfocado en acumular datos sobre el problema de la contaminación de suelos por microplásticos y determinar las principales rutas de entrada de estos contaminantes al suelo. Sin embargo, aún no nos hemos preocupado de evaluar los efectos que tienen sobre la flora y fauna o sobre la producción agrícola, así como tampoco hemos evaluado qué pasa con los microplásticos, una vez que entran a un sistema productivo”. El investigador de INIA comenta que, ahora que se conoce el problema, magnitud y distribución en algunos suelos de Chile, es posible avanzar y empezar a resolver otros puntos carentes de información. Por esta razón, INIA dará inicio a un nuevo proyecto, financiado por la Agencia Nacional de Investigación y Desarrollo (ANID), con el objetivo de evaluar el destino y transporte de los microplásticos en sistemas agrícolas. La investigación, que durará tres años, permitirá entender los principales flujos de microplásticos hacia y desde suelos agrícolas y evaluar los efectos del agua sobre el encapsulamiento o arrastre de microplásticos dentro y fuera del suelo. “Con la información que esperamos recabar en este estudio, buscaremos entender cómo, mediante prácticas de manejo, es posible mitigar los efectos de la contaminación por microplásticos y evitar su dispersión en el ambiente”, puntualizó el investigador de INIA.
Investigación chilena busca mitigar el efecto de los microplásticos en suelos agrícolas Leer más »